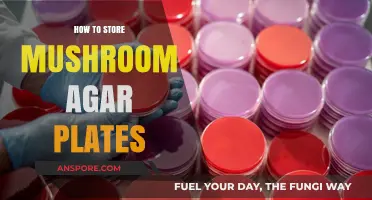
Proper Mushroom Agar Plate Storage: Tips for Longevity and Viability

Storing mushroom spore prints is a crucial step for mycologists, hobbyists, and enthusiasts looking to preserve fungal genetic material for future cultivation or study. Spore prints, which capture the spores released by a mushroom’s gills or pores, are delicate and require careful handling to maintain their viability. Proper storage involves creating a clean, dry environment to prevent contamination and degradation. Typically, spore prints are placed on a sterile surface like aluminum foil or glass, allowed to dry completely, and then sealed in an airtight container, such as a glass vial or envelope, often with a desiccant to absorb moisture. Labeling with details like the mushroom species, collection date, and location ensures accurate identification later. When stored in a cool, dark place, spore prints can remain viable for years, providing a valuable resource for research, cultivation, or educational purposes.
| Characteristics | Values |
|---|---|
| Storage Medium | Glass slides, aluminum foil, wax paper, or parchment paper |
| Container Type | Airtight containers (glass jars, plastic containers, or ziplock bags) |
| Desiccant Use | Silica gel packets to absorb moisture |
| Labeling | Include species name, collection date, and location |
| Temperature | Cool, dark place (room temperature or refrigerator for long-term storage) |
| Humidity Control | Keep humidity low to prevent mold growth |
| Light Exposure | Store in a dark place to prevent spore degradation |
| Duration of Storage | Up to several years if stored properly |
| Avoidance of Contaminants | Ensure tools and surfaces are clean to prevent contamination |
| Sealing Method | Use airtight seals or vacuum sealing for optimal preservation |
| Additional Protection | Place container in a secondary airtight bag for extra protection |
| Inspection Frequency | Periodically check for signs of mold or degradation |
Explore related products
What You'll Learn
- Preparation: Clean glass surface, drop alcohol, let dry, place mushroom cap, gills down, cover
- Collection: Check after 24 hours, gently lift mushroom, collect spores with clean tool
- Storage: Use paper envelopes, label with date/species, store in cool, dry, dark place
- Preservation: Add silica gel packets to envelopes to prevent moisture, ensure long-term viability
- Safety: Wear gloves, avoid inhaling spores, sanitize tools, work in well-ventilated area

Preparation: Clean glass surface, drop alcohol, let dry, place mushroom cap, gills down, cover
To begin the process of creating and storing mushroom spore prints, it's essential to start with a clean and sterile environment. The first step in Preparation: Clean glass surface, drop alcohol, let dry, place mushroom cap, gills down, cover is to thoroughly clean the glass surface you'll be using. Choose a clear, flat glass slide or a small glass dish, ensuring it's free from dust, debris, or any residues. Use a mild detergent or soap to wash the glass, rinse it well with water, and then dry it with a lint-free cloth or allow it to air dry. Once the glass is clean, sanitize it by wiping the surface with a small amount of isopropyl alcohol (rubbing alcohol) using a clean cloth or cotton swab. This step is crucial to prevent contamination of the spore print.
After cleaning the glass surface, the next step in Preparation: Clean glass surface, drop alcohol, let dry, place mushroom cap, gills down, cover is to let the alcohol evaporate completely. Place the glass slide or dish in a well-ventilated area, away from direct sunlight or heat sources, and allow it to air dry. This process should take only a few minutes, but it's vital to ensure that no alcohol residue remains on the surface, as it can affect the viability of the spores. While waiting for the glass to dry, prepare the mushroom cap by gently removing any dirt or debris from its surface using a soft brush or a clean, damp cloth. Be careful not to damage the delicate gills underneath the cap.
With the glass surface clean and dry, proceed to the next step in Preparation: Clean glass surface, drop alcohol, let dry, place mushroom cap, gills down, cover by carefully positioning the mushroom cap on the glass. Ensure the gills are facing downward, making direct contact with the glass surface. The gills contain the spores, and this orientation allows them to be released onto the glass as the mushroom cap rests. It's essential to handle the mushroom cap gently to avoid dislodging spores prematurely or damaging the gills. Leave the mushroom cap undisturbed for several hours, preferably overnight, to allow sufficient time for the spores to drop onto the glass surface.
As you reach the final stages of Preparation: Clean glass surface, drop alcohol, let dry, place mushroom cap, gills down, cover, it's time to secure the setup to prevent contamination and disturbance. Once the spores have been released onto the glass, carefully remove the mushroom cap, taking care not to smudge or disturb the spore print. Immediately cover the glass slide or dish with a clean, dry cover slip or a small piece of glass to protect the spore print from dust, moisture, and other contaminants. Alternatively, you can use a small, airtight container or a folded piece of paper to cover the spore print, ensuring it remains undisturbed. Properly covering the spore print is vital for its preservation and long-term storage.
The last step in Preparation: Clean glass surface, drop alcohol, let dry, place mushroom cap, gills down, cover involves labeling and storing the spore print for future use. Use a soft pencil or a fine-tipped marker to label the glass slide or container with the mushroom species, date of collection, and any other relevant information. Store the spore print in a cool, dark, and dry place, such as a drawer or a box, away from direct sunlight, heat, and moisture. When stored correctly, mushroom spore prints can remain viable for several years, providing a valuable resource for identification, study, or cultivation. By following these detailed steps, you can ensure the successful creation and storage of high-quality mushroom spore prints.
Strategies to Save the Mushroom Picker in BG3
You may want to see also

Collection: Check after 24 hours, gently lift mushroom, collect spores with clean tool
After preparing your mushroom and substrate for spore printing, the collection process is a delicate but straightforward task. Check after 24 hours to ensure the spores have had ample time to drop. If the mushroom’s gills are facing downward, you should see a fine, powdery deposit on the surface below. Avoid checking too early, as this may disrupt the spore release process. Once 24 hours have passed, carefully inspect the print to confirm that a sufficient amount of spores has been deposited. If the print appears incomplete, allow additional time, but avoid exceeding 48 hours to prevent contamination.
When the time is right, gently lift the mushroom from the substrate. Use a steady hand to avoid disturbing the spore print. Hold the mushroom by its stem, taking care not to touch the cap or gills, as oils from your skin can contaminate the spores. If the mushroom is adhered to the substrate, carefully slide a clean, sterile tool, such as a scalpel or spatula, underneath to loosen it. Place the mushroom aside on a clean surface or in a separate container to keep it sterile and ready for future use if desired.
With the mushroom removed, focus on collecting the spores with a clean tool. Use a sterile scalpel, spatula, or even a folded piece of paper to gently scrape the spore deposit from the substrate. Ensure the tool is free of contaminants to maintain the purity of the spores. Work slowly and methodically to avoid spilling or losing any spores. If using glass or foil as your substrate, the spores should easily lift off in a fine powder. For paper, you may carefully cut out the section with the spore print to preserve it intact.
Once collected, transfer the spores into a storage container immediately. Use a small, sterile vial or envelope labeled with the mushroom species and collection date. Glass vials with airtight seals are ideal for long-term storage, as they protect the spores from moisture and contaminants. If using an envelope, ensure it is made of acid-free paper and sealed securely. Store the container in a cool, dark place, such as a refrigerator or a dedicated storage box, to preserve the viability of the spores for future cultivation or study.
Finally, clean and sterilize all tools and surfaces used during the collection process to prevent cross-contamination. Proper hygiene ensures that your spore prints remain pure and viable for extended periods. With careful collection and storage, your mushroom spore prints can serve as a valuable resource for mycological research, cultivation, or artistic endeavors. Always handle spores with respect for their delicate nature and the potential they hold.
Mexican Mushrooms: A Guide to the Magic and Benefits
You may want to see also

Storage: Use paper envelopes, label with date/species, store in cool, dry, dark place
Storing mushroom spore prints properly is essential to ensure their longevity and viability for future use. One of the most effective and straightforward methods is to use paper envelopes for storage. Paper envelopes are ideal because they are breathable, which helps prevent moisture buildup that could lead to mold or degradation of the spores. Avoid using plastic bags or airtight containers, as these can trap humidity and damage the spore print. When selecting envelopes, opt for acid-free or archival-quality paper to minimize the risk of chemical reactions that could harm the spores over time.
Once you have your paper envelope, it’s crucial to label it with the date and species of the mushroom. This information is vital for future reference, as it helps you identify the spore print and track its age. Use a permanent, waterproof marker or pen to ensure the label remains legible over time. Include additional details such as the location where the mushroom was found and any unique characteristics of the specimen. Proper labeling not only aids in organization but also ensures that you can use the spore print effectively for cultivation or study in the future.
After labeling, place the spore print carefully into the envelope. If the spore print is on a piece of paper or foil, fold it gently to fit inside without disturbing the spores. Seal the envelope securely, but avoid excessive folding or creasing, as this could damage the spore print. Once the envelope is prepared, it’s time to focus on the storage environment. The ideal location is a cool, dry, and dark place. Excess heat, moisture, or light can degrade the spores, reducing their viability. A drawer, cabinet, or storage box in a temperature-stable room works well. Avoid areas prone to temperature fluctuations, such as attics, basements, or near windows.
To further protect your spore prints, consider adding a desiccant packet to the storage container. This helps maintain low humidity levels and prevents moisture-related issues. If using a storage box, ensure it is airtight and opaque to block out light. Periodically check the storage area to ensure conditions remain optimal. With proper storage, mushroom spore prints can remain viable for several years, allowing you to preserve and utilize them for cultivation, research, or educational purposes.
Finally, organize your stored spore prints systematically for easy access. Arrange envelopes alphabetically by species or chronologically by collection date, depending on your preference. Keep a digital or physical inventory list to track your collection and note any observations or usage over time. By following these steps—using paper envelopes, labeling accurately, and storing in a cool, dry, dark place—you can effectively preserve mushroom spore prints and ensure they remain a valuable resource for your mycological endeavors.
Shiitake Mushrooms: Light or Dark?
You may want to see also
Explore related products

Preservation: Add silica gel packets to envelopes to prevent moisture, ensure long-term viability
Storing mushroom spore prints effectively is crucial for preserving their viability over extended periods. One of the most reliable methods to achieve this is by adding silica gel packets to the storage envelopes. Silica gel is a desiccant that absorbs moisture, creating a dry environment essential for preventing mold growth and maintaining spore integrity. When preparing to store spore prints, start by selecting high-quality envelopes made of acid-free paper to avoid chemical degradation. Place the spore print carefully inside the envelope, ensuring it is not folded or damaged, as this could affect the spores' usability.
Once the spore print is securely placed, add one or two silica gel packets to the envelope. The number of packets depends on the envelope size and the humidity of the storage environment. Silica gel packets are widely available and come in various sizes, making them easy to incorporate into your preservation method. Ensure the packets are intact and free from tears to prevent spillage, which could contaminate the spore print. Seal the envelope tightly, removing as much air as possible to minimize exposure to moisture and other environmental factors.
For added protection, consider double-enveloping the spore print. Place the initial envelope containing the spore print and silica gel packets into a second, larger envelope. This extra layer provides additional insulation against humidity and physical damage. Label both envelopes with essential details such as the mushroom species, date of collection, and storage conditions. Proper labeling ensures easy identification and tracking, especially if you are storing multiple spore prints.
Store the sealed envelopes in a cool, dark, and dry place, such as a drawer or cabinet, away from direct sunlight and temperature fluctuations. Silica gel packets can be recharged by heating them in an oven at a low temperature, typically around 225°F (107°C) for a few hours, allowing them to be reused. However, if the packets change color (indicating they are saturated), replace them with fresh ones to maintain optimal dryness. Regularly inspect the storage area and envelopes for any signs of moisture or damage, ensuring the long-term viability of your mushroom spore prints.
By incorporating silica gel packets into your storage method, you create an environment that significantly extends the lifespan of mushroom spore prints. This technique is particularly valuable for mycologists, hobbyists, and researchers who rely on preserved spores for cultivation, study, or conservation efforts. The simplicity and effectiveness of this preservation method make it a go-to choice for anyone looking to safeguard their spore prints for years to come.
Mushroom Farming: Sustainable Superfood?
You may want to see also

Safety: Wear gloves, avoid inhaling spores, sanitize tools, work in well-ventilated area
When handling mushroom spore prints, prioritizing safety is crucial to protect yourself and ensure the integrity of the spores. Wear gloves at all times during the process. Gloves act as a barrier, preventing direct contact between your skin and the spores, which can cause irritation or allergic reactions in some individuals. Latex or nitrile gloves are ideal, as they are durable and provide a good grip. Ensure the gloves fit snugly to avoid any accidental contamination or exposure.
Another critical safety measure is to avoid inhaling spores. Mushroom spores are microscopic and can become airborne during handling, posing a risk if inhaled. To minimize this, work slowly and deliberately, avoiding any abrupt movements that could disturb the spores. If you are particularly sensitive or have respiratory issues, consider wearing a mask designed to filter out fine particles. This extra precaution can significantly reduce the risk of inhaling spores and potential health complications.
Sanitizing your tools is essential to prevent contamination of the spore print and to maintain a sterile environment. Before and after handling spore prints, clean all tools—such as scalpels, tweezers, and storage containers—with isopropyl alcohol or another suitable disinfectant. Allow the tools to air dry completely before use to avoid introducing moisture, which can degrade the spore print. Keeping your workspace and tools clean ensures the longevity and viability of the stored spores.
Working in a well-ventilated area is equally important to maintain safety and comfort. Good ventilation helps disperse any airborne spores, reducing the risk of inhalation and creating a healthier environment. If possible, work near an open window or use a fan to improve air circulation. Avoid working in confined spaces, as poor ventilation can increase the concentration of spores in the air. A well-ventilated workspace not only protects you but also minimizes the risk of cross-contamination.
Lastly, combine these safety practices for maximum effectiveness. For example, wear gloves while sanitizing tools to avoid transferring contaminants. Always be mindful of your movements to prevent spore dispersal, especially in a well-ventilated area where air movement is higher. By adhering to these safety guidelines—wearing gloves, avoiding spore inhalation, sanitizing tools, and working in a well-ventilated area—you can safely and successfully store mushroom spore prints while protecting your health and the quality of the spores.
Mushroom Magic: Unlocking Skin Benefits and Beauty Secrets Naturally
You may want to see also
Frequently asked questions
Store spore prints in a cool, dark, and dry place, such as a sealed envelope or glassine paper inside an airtight container. Keep them at room temperature or in a refrigerator for extended preservation.
Avoid using plastic bags as they can trap moisture, leading to mold or degradation of the spores. Instead, use paper envelopes or glassine paper for better airflow and protection.
Properly stored spore prints can remain viable for several years, often up to 5–10 years or more, depending on the species and storage conditions.
Yes, always label spore prints with the mushroom species, collection date, and location to ensure accurate identification and tracking for future use.
Freezing is not recommended as it can damage the delicate spores. Stick to cool, dry storage methods for optimal preservation.



![Art Photo Storage Box Eternity Archival Clamshell Box For Storing Artwork, Photos & Documents Deluxe Acid-Free Sturdy & Lined With Archival Paper - [Black - 8.5" x 11"]](https://m.media-amazon.com/images/I/91sazmP78eL._AC_UY218_.jpg)